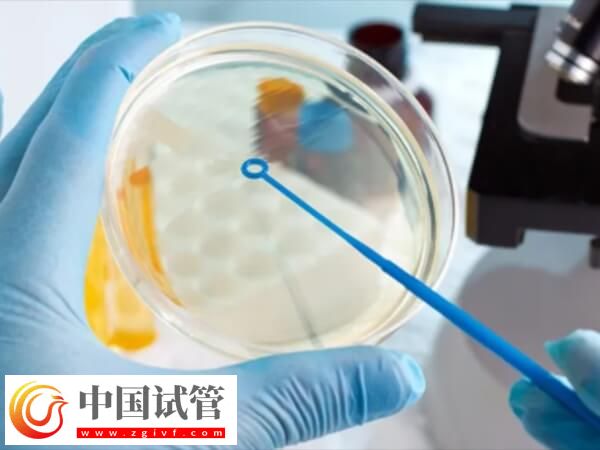
試管嬰兒建檔后流程是怎么樣的(圖1)

亚洲国产精品成人久久综合一区_国产日产精品一区_国产一区在线观看麻豆_亚洲精品久久久蜜桃
久久综合色影院|
亚洲最新中文字幕|
国产在线成人|
亚洲第一福利视频|
日韩西西人体444www|
亚洲欧美国产日韩天堂区|
久久精品国语|
欧美日韩高清在线|
国产精品久久久久久亚洲毛片|
国产日韩专区|
亚洲精品网站在线播放gif|
亚洲欧美激情四射在线日|
久久影院午夜片一区|
欧美另类在线播放|
国产午夜精品久久久|
日韩午夜在线观看视频|
久久成人精品无人区|
欧美日韩国产丝袜另类|
国产亚洲观看|
夜夜狂射影院欧美极品|
久久人人爽爽爽人久久久|
欧美性jizz18性欧美|
国产在线精品成人一区二区三区|
日韩一级大片在线|
久久久久久久999精品视频|
欧美日韩综合网|
在线观看视频一区二区|
午夜精品久久久久久久久
|
欧美在线关看|
欧美日韩视频专区在线播放
|
国产精品99久久久久久人|
久久中文欧美|
国产欧美va欧美va香蕉在|
99xxxx成人网|
麻豆久久精品|
国产亚洲精品高潮|
亚洲一区999|
欧美精品日韩精品|
伊人久久大香线|
欧美亚洲午夜视频在线观看|
欧美日韩亚洲高清一区二区|
亚洲第一主播视频|
欧美在线视频免费观看|
国产精品福利在线观看|
亚洲激情中文1区|
久久久五月天|
国产人成一区二区三区影院|
中日韩午夜理伦电影免费|
欧美成人激情视频免费观看|
国产一区二区三区在线播放免费观看|
亚洲特黄一级片|
欧美另类亚洲|
最新亚洲激情|
免费看成人av|
悠悠资源网亚洲青|
久久久五月天|
国内精品99|
久久av一区二区三区|
国产伦精品一区二区三区视频黑人
|
欧美日韩在线三级|
亚洲精品一区二区三区99|
老色批av在线精品|
激情视频一区二区|
久久久91精品国产|
国产一区二区三区久久久|
性欧美暴力猛交69hd|
国产精品自拍在线|
亚洲欧美日韩综合aⅴ视频|
国产精品久久久91|
亚洲影院在线观看|
国产精品久久久久三级|
亚洲性视频网站|
国产精品久久久久久妇女6080|
亚洲深夜福利视频|
国产精品www.|
亚洲免费视频成人|
国产精品亚洲一区二区三区在线|
亚洲免费在线电影|
国产精品欧美一区喷水|
午夜精品视频在线观看一区二区
|
亚洲国产成人av|
欧美99在线视频观看|
亚洲区第一页|
欧美日韩国产123|
一本色道久久综合亚洲二区三区|
欧美日韩精品免费观看|
一区二区三区久久网|
国产精品高潮呻吟久久av黑人|
亚洲欧美日韩电影|
国产一区二区日韩|
久久乐国产精品|
最新成人在线|
欧美日韩精品免费观看视频完整|
一区二区三区高清不卡|
国产精品美女诱惑|
欧美中文在线字幕|
樱花yy私人影院亚洲|
欧美大片在线看|
99精品免费网|
国产精品久久久久三级|
欧美中文字幕在线播放|
伊人一区二区三区久久精品|
欧美黑人在线观看|
亚洲视频在线一区观看|
国产麻豆精品theporn|
久久精品青青大伊人av|
亚洲国产婷婷|
欧美视频在线观看视频极品|
欧美亚洲综合另类|
在线看成人片|
欧美日韩美女在线|
午夜精品美女久久久久av福利|
一区二区三区在线看|
欧美久久一级|
午夜精品久久久久久久99水蜜桃|
韩国欧美国产1区|
欧美精品国产|
性xx色xx综合久久久xx|
亚洲电影欧美电影有声小说|
欧美日精品一区视频|
久久精品72免费观看|
亚洲精品人人|
国产日韩精品一区二区|
免费久久99精品国产|
亚洲伊人一本大道中文字幕|
一区二区三区在线观看视频|
欧美日韩在线直播|
久久精品视频免费播放|
夜夜嗨一区二区|
国内一区二区三区|
欧美日韩性生活视频|
久久精品国产精品亚洲精品|
亚洲区一区二|
国产日韩欧美不卡|
欧美噜噜久久久xxx|
久久久国产午夜精品|
在线一区二区三区四区|
黑人极品videos精品欧美裸|
欧美精品三级日韩久久|
久久激情视频免费观看|
日韩视频亚洲视频|
国内不卡一区二区三区|
欧美天堂亚洲电影院在线播放|
久久婷婷国产综合精品青草|
亚洲视频精选|
亚洲国产高潮在线观看|
国产精品资源在线观看|
欧美日韩dvd在线观看|
久久精品视频播放|
宅男噜噜噜66一区二区|
亚洲国产精品va在线观看黑人
|
亚洲激情黄色|
国产亚洲制服色|
欧美午夜激情视频|
欧美国产一区二区|
久久精品夜色噜噜亚洲a∨|
亚洲一区视频|
亚洲精品日韩欧美|
一区二区三区在线观看欧美|
国产精品久久一卡二卡|
欧美激情一区二区在线
|
欧美视频在线看|
欧美精品久久久久久久久老牛影院|
久久激情一区|
亚洲欧美日韩精品一区二区
|
久久精品国产一区二区三区免费看|
99精品国产在热久久下载|
亚洲国产成人精品女人久久久|
国产三级精品三级|
国产精品wwwwww|
欧美精品在线网站|
欧美大片一区二区|
久热精品视频在线免费观看
|
欧美性猛交xxxx乱大交蜜桃|
欧美精品尤物在线|
美女网站久久|
久久视频在线视频|
久久动漫亚洲|
欧美影院一区|
午夜精品国产精品大乳美女|
亚洲丝袜av一区|
9色精品在线|
亚洲美女av网站|
亚洲日本激情|
亚洲精品色婷婷福利天堂|
91久久精品日日躁夜夜躁欧美|
在线观看欧美黄色|
伊人狠狠色丁香综合尤物|
狠狠综合久久av一区二区老牛|
国产日韩欧美综合|
国产日韩精品一区观看|
国产欧美一区二区精品性|
国产精品五月天|
国产欧美va欧美不卡在线|
国产欧美日韩精品在线|
国产欧美一区二区三区国产幕精品
|
国产日韩欧美二区|
国产精品视频不卡|
国产精品久久久久久久久免费桃花|
欧美视频精品在线|
国产精品免费福利|
国产精品揄拍500视频|
国产午夜亚洲精品不卡|
国产一区二区欧美日韩|